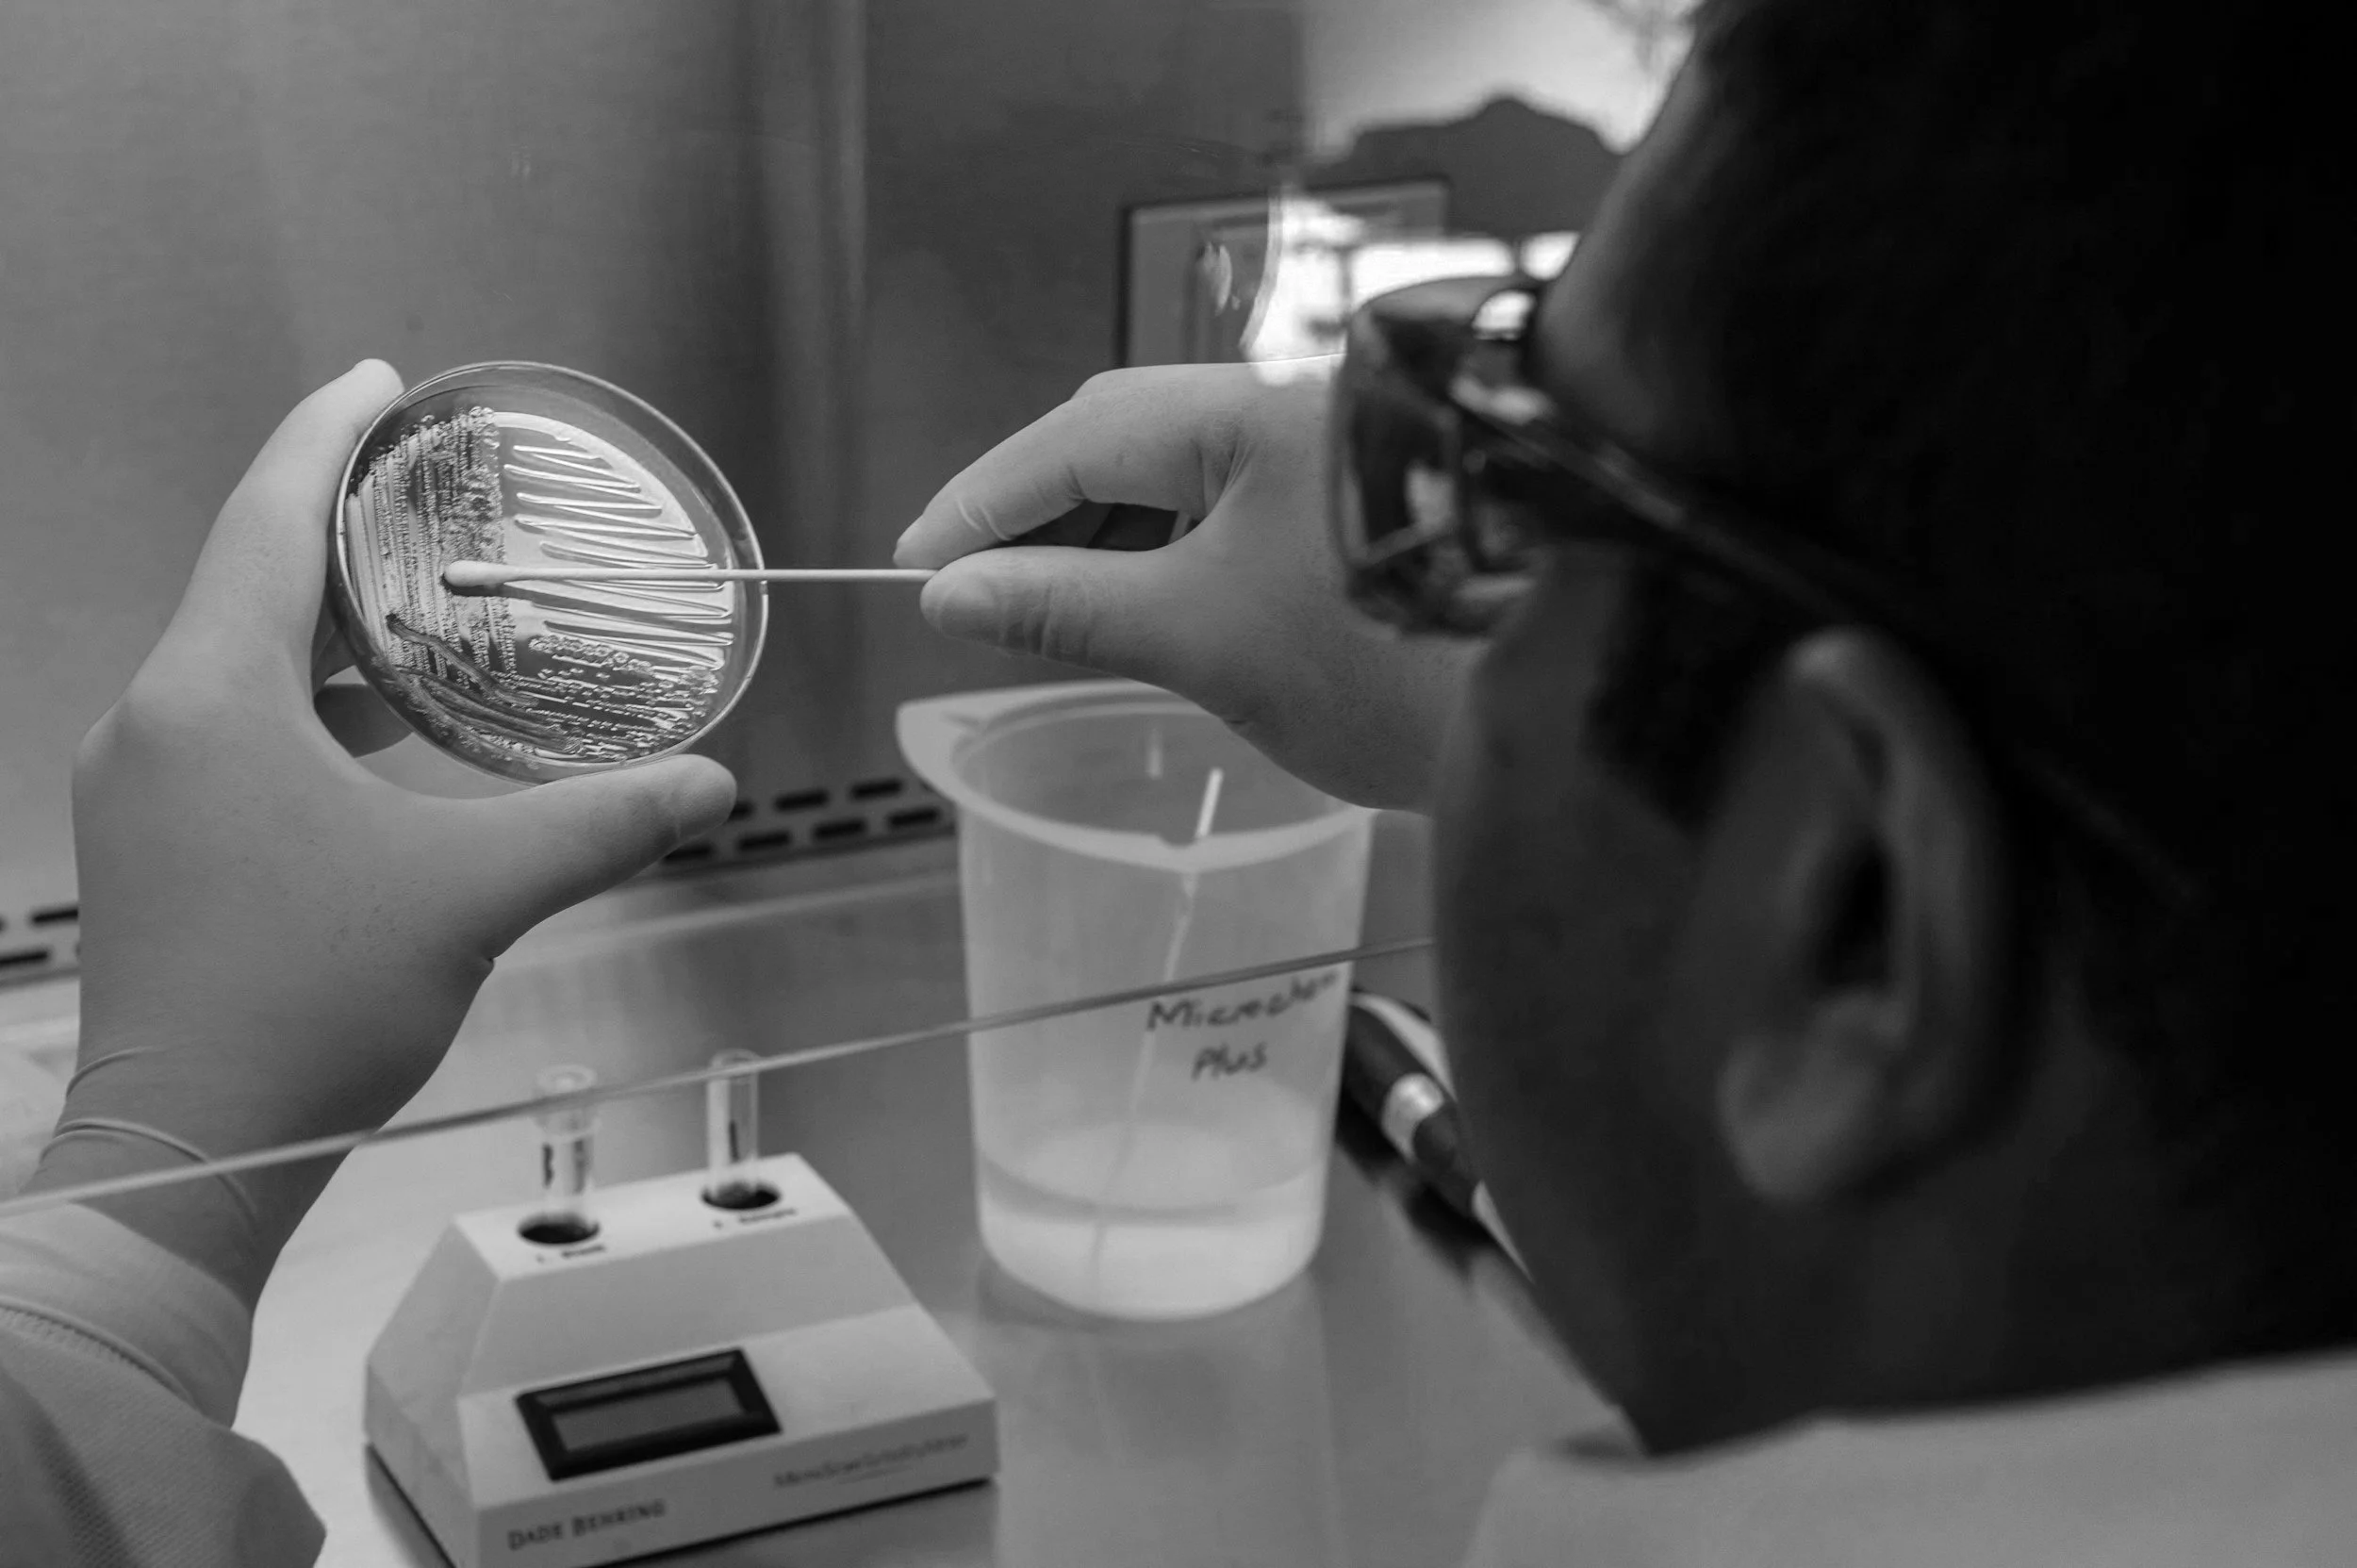

Workshop Resources
Workshop Resources
You will have received a password from a workshop or webinar to access the relevant resources

Contact us.
To learn more about offerings or to schedule a workshop
